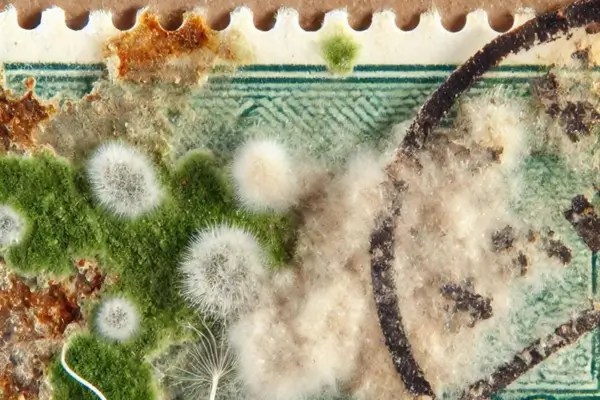
Como Detectar e Tratar Fungos em Selos Históricos

Luz vs. Escuridão: Como a Exposição à Luz Pode Danificar Seus Selos Históricos
A coleção de selos históricos não é apenas um hobby fascinante; é também uma forma de preservar fragmentos valiosos da…

A coleção de selos históricos não é apenas um hobby fascinante; é também uma forma de preservar fragmentos valiosos da…

Os selos de patrimônio mundial são emissões filatélicas que celebram e homenageiam locais, monumentos e tradições culturais reconhecidos por sua…
A preservação de selos históricos é uma prática vital para qualquer colecionador, pois esses pequenos pedaços de papel não são…

Os selos históricos são mais do que simples pedaços de papel. Eles são testemunhas silenciosas de eventos marcantes, portadores de…

A avaliação de selos antigos é uma prática que remonta aos primórdios do colecionismo, quando entusiastas e especialistas utilizavam métodos…

A filatelia, ou o ato de colecionar e estudar selos postais, é uma atividade que transcende gerações, combinando a paixão…

Desde os primórdios do sistema postal, os selos têm servido como mais do que apenas comprovantes de pagamento de tarifas;…

No vasto e fascinante universo da filatelia, os selos temáticos ocupam um lugar especial. Estes pequenos pedaços de história e…

A arte e a filatelia, à primeira vista, podem parecer universos distintos, mas quando olhamos mais de perto, descobrimos que…

Transportar selos de forma segura é uma das principais preocupações de qualquer colecionador sério. Os selos, além de serem peças…